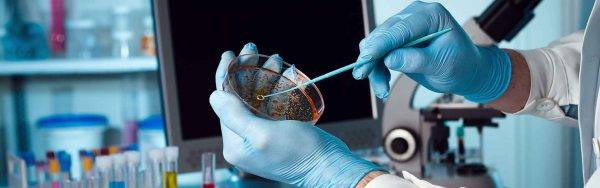

Коронавирус у кошек — заболевание, вызывающее беспокойство у владельцев и ветеринаров. Хотя инфекция отличается от COVID-19, она может иметь серьезные последствия для здоровья животных. В статье рассмотрим основные симптомы, методы диагностики и эффективные способы лечения, что поможет владельцам распознать болезнь и оказать помощь своим питомцам. Знание этих аспектов важно для здоровья кошек и предотвращения распространения инфекции среди других животных.
Общая характеристика заболевания
Коронавирусы представляют собой группу вирусов, которые могут инфицировать как животных, так и людей. Их отличительной чертой является структура, напоминающая корону. Внешняя оболочка вируса, известная как суперкапсид, содержит шипы, которые выглядят как тонкие «ножки» с округлыми головками. Последний обнаруженный коронавирус вызывает заболевание, известное как COVID-19. Основные симптомы этого заболевания включают поражение дыхательной системы и органов пищеварения, при этом чаще всего наблюдаются респираторные проявления, и его диагностируют как ОРВИ.
Коронавирусы обладают определенными характеристиками, среди которых низкая устойчивость к внешним воздействиям. Они хорошо переносят низкие температуры, но не выносят высоких температур. Вирус погибает при температуре выше 56 градусов по Цельсию. Кроме того, коронавирусы разрушаются под действием этилового спирта, формалина и ряда других химических веществ.
Эксперты в области ветеринарной медицины подчеркивают, что коронавирус у кошек, хотя и менее распространен, чем у людей, все же представляет собой серьезную угрозу для здоровья домашних питомцев. Симптомы инфекции могут варьироваться от легких до тяжелых и включают в себя рвоту, диарею, потерю аппетита и вялость. Важно отметить, что некоторые кошки могут быть носителями вируса и не проявлять никаких признаков заболевания, что усложняет диагностику. В случае подозрения на инфекцию ветеринары рекомендуют немедленно обратиться за помощью, так как ранняя диагностика и лечение могут значительно повысить шансы на выздоровление. Лечение обычно включает поддерживающую терапию, направленную на облегчение симптомов и укрепление иммунной системы животного. Профилактика также играет ключевую роль, и владельцам следует соблюдать меры предосторожности, такие как ограничение контактов с потенциально инфицированными животными.

Основные меры профилактики коронавирусной инфекции
Вот основные меры профилактики, которые должен соблюдать каждый человек:
Не прикасаться руками к лицу. Ученые подсчитали, что в
среднем человек за час 25 раз трогает свое лицо руками. При этом этими же
руками люди касаются разных поверхностей, на которых может обитать вирус. В
половине случаев заражение происходит посредством проникновения вируса через
слизистые – глаза, рот, нос.
Мыть руки. Такая вроде бы простая и элементарная
процедура на настоящий момент считается самой эффективной профилактикой
COVID-19. Руки надо мыть как можно чаще, причем делать это нужно в течение
40-60 секунд. Если вы моете руки в общественном месте, кран после мытья рук
следует закрывать одноразовым полотенцем, которым вы вытерли руки.
Рекомендуется использовать жидкое мыло, так как на твердом мыле могут остаться микроорганизмы.
Использовать антисептики
Длительность обработки рук
составляет 20-30 секунд
Но при покупке данных средств важно обращать внимание
на состав. Рекомендуемая концентрация – 80% этанола, 1,45% глицерина, 0,125%
перекиси водорода.
Если во время чихания и кашля прикрывать рот и нос,
экспансию COVID-19 можно предотвратить
Кашлять и чихать нужно в салфетку, а
если ее под рукой нет – в сгиб локтя
После использования салфетки, ее нужно
сразу же выбросить в мусорный контейнер. Многие люди прикрывают рот и нос во
время кашля и чихания ладонями – это неправильно и достаточно опасно. Вирус
попадает на руки, которыми человек впоследствии прикасается к различным
предметам.
Носить маску. Данное изделие предназначено для больных
людей, а также для тех, кто ухаживает за больными. Маска должна плотно
прилегать к лицу, зазоров не должно оставаться. Менять маску нужно каждые 2-3
часа, повторно использовать ее нельзя.
Избегать близких контактов, оставаться на
самоизоляции. Специалисты советуют держаться от других людей на расстоянии не
менее 1 мера. О рукопожатиях, а тем более об объятиях следует пока забыть.
Лучшим вариантом является домашняя самоизоляция.
Проветривание помещения. Приток свежего воздуха
снижает вирусную нагрузку.
Профилактика коронавируса — рекомендации Роспотребнадзора
Отдельно надо сказать о профилактике для пожилых людей. Риск заражения после 65 лет увеличивается, особенно тяжело вирусная инфекция протекает у лиц, имеющих хронические заболевания. Пожилым людям рекомендуется оставаться дома и ограничить близкие контакты с другими людьми, при общении обязательно соблюдать дистанцию.
Конечно пожилым людям следует доставлять продукты питания и необходимые лекарства, но, приходя к ним, следует обязательно надевать маску. Это связано с тем, что многие люди переносят инфекцию в очень легкой форме, не имеют клинических симптомов, но являются потенциально заразными.
Как не заразиться коронавирусом — рекомендации Роспотребнадзора
Дорогой читатель, мы собрали всю самую важную и актуальную информацию о COVID-19 на 1 странице — главное о коронавирусе.Также, доступна актуальная статистика по: России, Москве, Подмосковью и городам, СпБ и всем регионам РФ и странам мира.
Если пожилые родственники проживают вместе с вами, их нужно поселить в отдельную, хорошо проветриваемую комнату, при общении с ними надевать маску и почаще дезинфицировать поверхности.
Мерами профилактики для пожилых людей являются:
- Оставаться дома, избегать поездок в общественном транспорте, не находиться в местах массового скопления людей.
- Заказывать продукты с доставкой на дом или через родственников.
- Укреплять иммунитет при помощи витаминов и других средств.
- Делать чаще влажную уборку, проветривать помещение.
| Категория | Симптомы | Лечение и рекомендации |
|---|---|---|
| Общие симптомы | Вялость, снижение активности | Обеспечение покоя, комфортной температуры, доступ к свежей воде |
| Снижение аппетита, отказ от еды | Предложение легкоусвояемой, вкусной пищи, возможно, подогретой | |
| Повышенная температура тела (лихорадка) | Консультация ветеринара, жаропонижающие средства по назначению | |
| Респираторные симптомы | Чихание, кашель | Поддержание чистоты носовых проходов, увлажнение воздуха |
| Выделения из носа и глаз (прозрачные или гнойные) | Промывание глаз и носа физиологическим раствором, антибиотики при гнойных выделениях (по назначению) | |
| Затрудненное дыхание, одышка | Немедленное обращение к ветеринару, кислородная терапия | |
| Пищеварительные симптомы | Рвота, диарея | Диета, пробиотики, противорвотные/противодиарейные средства (по назначению) |
| Обезвоживание | Подкожные или внутривенные инфузии жидкости (по назначению ветеринара) | |
| Специфические симптомы (при FIP) | Увеличение живота (при влажной форме FIP) | Симптоматическая терапия, противовирусные препараты (по назначению, в зависимости от доступности и эффективности) |
| Потеря веса, анемия | Поддерживающая терапия, витамины, препараты железа | |
| Неврологические нарушения (судороги, атаксия) | Противосудорожные препараты, поддерживающая терапия | |
| Профилактика и уход | Вакцинация (от некоторых вирусных инфекций, не от коронавируса кошек напрямую) | Регулярная вакцинация по графику, рекомендованному ветеринаром |
| Поддержание гигиены | Регулярная уборка лотка, мисок, игрушек, дезинфекция поверхностей | |
| Изоляция больного животного | Отделение больной кошки от здоровых, использование отдельных мисок и лотков | |
| Снижение стресса | Создание спокойной обстановки, достаточное внимание и игры | |
| Регулярные визиты к ветеринару | Профилактические осмотры, своевременное выявление и лечение заболеваний |
Интересные факты
Вот несколько интересных фактов о коронавирусе у кошек:
-
Форма вируса: Коронавирус у кошек (FCoV) имеет две основные формы: обычный коронавирус, который может вызывать легкие желудочно-кишечные расстройства, и более опасная форма — инфекционный перитонит кошек (FIP), который может быть смертельным. FIP возникает, когда обычный коронавирус мутирует внутри организма кошки.
-
Передача вируса: Коронавирус у кошек передается через фекалии зараженных животных. Это означает, что кошки, которые живут в многокошачьих домах или приютах, имеют более высокий риск заражения. Однако, несмотря на это, коронавирус не передается человеку.
-
Лечение и профилактика: На данный момент нет специфического лечения для коронавируса у кошек, особенно для FIP. Однако в последние годы появились новые противовирусные препараты, которые показывают обнадеживающие результаты в лечении FIP. Профилактика включает в себя поддержание чистоты в местах обитания кошек и минимизацию стресса, что может помочь снизить риск заражения.

Признаки коронавируса Дельта у взрослого
В октябре 2020 года в Индии был зафиксирован новый штамм опасного вируса, получивший название «Дельта». На сегодняшний день он обнаружен более чем в 100 странах по всему миру. Врачи настоятельно призывают к осторожности, подчеркивая, что этот штамм в два раза более заразен и опасен, чем уханьский и другие предыдущие варианты. В отличие от них, «Дельта» передается быстрее через контакт, а инкубационный период проходит практически незаметно. Среди основных симптомов коронавируса «Дельта» у взрослых можно выделить:
- болевые ощущения в суставах;
- потерю слуха и аппетита;
- усиливающуюся боль в животе;
- тошноту и диарею;
- насморк и першение в горле.
Симптоматика чаще всего проявляется у взрослых постепенно. Все начинается, как при обычной простуде, с головной боли и насморка. Если заболевание прогрессирует, к этим симптомам добавляются кашель и высокая температура. Поэтому многие не спешат обращаться к врачам, принимая свое состояние за обычную простуду. Серьезные симптомы обычно возникают на 4-7 день, когда появляются сильные боли в животе и диарея. При этом почти всегда у заболевших не наблюдается потеря обоняния, как это бывает при других вариантах SARS-CoV-2.
Согласно данным вирусологов, новый штамм может с высокой вероятностью обходить защиту антител.
Профессор кафедры вирусологии биологического факультета МГУ Алексей Аграновский в интервью радио Sputnik отметил, что новым штаммам следует уделять внимание, однако паниковать не стоит. По его мнению, «Дельта» настолько эффективно заражает людей, что другим штаммам просто не остается места: инкубационный период штамма SARS-CoV-2 «Дельта» составляет от 2,5 до 5 дней, и другие мутации не успевают за ним.
Симптомы последствия коронавируса
За время пандемии врачи накопили значительный опыт в диагностике и лечении последствий коронавирусной инфекции. Было выявлено несколько характерных симптомов, которые объединили в так называемый «постковидный синдром» или «лонг-ковид». Сегодня считается, что постковид – это продолжение болезни после выхода человека из острой фазы.
Первое, что нужно помнить, постковидный синдром проявляется далеко не у всех заболевших. Все-таки большинство населения переносит коронавирусную инфекцию в легкой форме. И второе – чем тяжелее протекала болезнь, тем ярче выражена симптоматика постковида.
Бессонница, аритмия, дыхательная недостаточность, разного рода нарушения обмена веществ. Но те, у кого была диагностирована пневмония, неврологические нарушения, тромбозы, восстанавливаются дольше других.
Часто отмечаются психосоматические симптомы после перенесенной COVID-19 инфекции, а также посттравматическое стрессовое расстройство, когда требуется помощь психотерапевта или психиатра.
Коронавирусная инфекция коварна тем, что зачастую протекает незаметно, а впоследствии идет мгновенное нарастание симптоматики. Поэтому нужно быть всегда начеку, и при малейших признаках недомогания или после контакта с больным лучше лишний раз показаться врачу и убедиться, что все в порядке.
Компьютерная томография в ОН КЛИНИК
Остались вопросы? Хотите узнать больше и уточнить цены?
Вы можете связаться с нами по телефону+7 (910) 123-45-67 или Закажите звонок

Хламидиоз
Хламидиоз — это инфекционное заболевание, которое чаще всего становится причиной острых конъюнктивитов у кошек. Наиболее подвержены этому недугу котята, поскольку инфекция может передаваться им внутриутробно, однако также существует риск заражения и взрослых животных.
Среди общих клинических проявлений хламидиоза можно выделить легкие симптомы, связанные с поражением верхних дыхательных путей, такие как усиленное чихание и выделения из носа. В некоторых источниках упоминаются случаи периодической рвоты и диареи, однако основным признаком заболевания является одно- или двухсторонний конъюнктивит. Из глаз выделяется обильное серозное или гнойное содержимое, наблюдаются блефароспазм и отек конъюнктивы. Инфекция передается от одного животного к другому через мочеполовую и желудочно-кишечную системы. При заражении взрослых кошек важным фактором является скученное содержание и использование общих предметов гигиены.
Диагностика хламидиоза у кошек может осуществляться различными методами, эффективность которых варьируется в зависимости от стадии заболевания. Например, при ранней диагностике, на 4-7 день после заражения, бактериальные тельца можно обнаружить в соскобах со слизистой конъюнктивы. Серологические исследования дают наиболее точные результаты, если их проводить в динамике: в течение 4-х недель после предполагаемого заражения наблюдается рост титра антител. На сегодняшний день наиболее надежным методом диагностики является ПЦР.
Лечение хламидиоза у животных возможно и осуществляется с помощью длительного курса антибиотикотерапии.
Наиболее эффективной мерой профилактики является вакцинация, которая обеспечивает надежную защиту на протяжении года. Кроме того, важно соблюдать общие профилактические меры, такие как выполнение зоогигиенических требований, карантин для новых животных и регулярная диспансеризация.
Анализы и диагностика на коронавирус
Если кошка заразилась коронавирусом, важно, как можно раньше начать лечение. А для этого лучше подстраховаться и сдать анализ, даже при отсутствии видимых признаков болезни у питомца
Ведь может сохраняться вирусоносительство без клинических проявлений. Тем самым можно обезопасить других питомцев, проживающих в доме.
Определенного анализа на обнаружение КВК-инфекции нет. Диагностика включает несколько этапов:
- ИХА/ИФА крови или плазмы. Определяет значение концентрации антител к вирусу. Пониженный уровень свидетельствует о слабом иммунитете, когда организм животного не способен дать должный отпор патогенным атакам, но это не означает отсутствие инфекции. При наличии вируса анализ положительный, но где он локализовался (в тканях или кишечнике) – неизвестно.
- ПЦР/ИХА фекалий. Позволяет выявить вирус в кошачьих испражнениях. Положительная реакция говорит о инфицировании животного, что требует его полной изоляции от остальных – здоровых. Если анализ отрицательный, возможно кошка является носителем вируса без его выделения во внешнюю среду.
- Сдача крови на ПЦР, определяющий коронавирус у кошек. Это один из самых неточных методов, часто показывающий ошибочные показатели.
- Титр антител. Дает возможность определить количество антител в сыворотке крови, что показывает степень поражения. На основании установленных значений врач может назначить правильную схему лечения, дать точный прогноз развития событий.
Наиболее простыми методами лабораторной диагностики инфекционного перитонита считаются биопсия и гистологические исследования тканей. Только это сложные и дорогостоящие процедуры, которые проводятся не в каждой ветклинике. Бывает, что для установления точного диагноза приходится прибегать к целому ряду анализов и тестов.
Установить кошачий коронавирус возможно только после сдачи не одного анализа
Что делать при положительном анализе
Если результаты анализа показывают положительный ответ, необходимо провести дополнительные исследования. В их состав входят:
- биохимический анализ крови;
- титровый тест на уровень белковых фракций в крови;
- повторный серологический анализ.
При подтверждении инфицирования перитонитом животному назначается пункция брюшной полости для анализа скопившейся жидкости.
Так выглядит тест с положительным результатом.
Владельцам не стоит паниковать в такой ситуации. Не обязательно, что инфекция перейдет в тяжелую форму, не поддающуюся лечению (FIP). Что следует сделать в первую очередь:
- По возможности изолировать здоровых животных от заболевшего. Если это невозможно, каждому питомцу нужно организовать отдельный лоток, миску и совок. Туалеты должны находиться как можно дальше от места кормления.
- Каждый день очищать лотки и обрабатывать их дезинфицирующими средствами (например, хлоркой). Лучше всего не использовать наполнитель. Миски после мытья следует обдавать кипятком. Питьевую воду менять дважды в день.
- Заменить текстиль в комнате на тот, который легко стирать. Желательно убрать ковры, так как их регулярная чистка может быть затруднительной. Пылесос в этом случае не самый лучший вариант, так как поток воздуха может разносить инфекцию.
- Установить в помещении ионизирующие очистители воздуха. Если есть возможность, периодически включать УФ-лампы, которые эффективно уничтожают микробы.
- Один раз в день обрабатывать рот животного травяным настоем из ромашки и коры дуба. Это не только дезинфицирует, но и укрепляет слизистую.
- Отменить все запланированные мероприятия: вязку, выставки и прочее.
- Перевести питомца на специальный режим питания, исключив все жирные продукты.
- Постараться минимизировать стрессовые ситуации для животного. В течение ближайших двух месяцев не проводить кастрацию (стерилизацию) и другие процедуры, которые могут вызвать стресс.
К сожалению, при коронавирусной инфекции говорить о полном выздоровлении не приходится. При выявлении этой инфекции у животного ветеринар назначает симптоматическое лечение, которое помогает локально справляться с проявлениями заболеваний (печеночная дисфункция, длительная диарея, асцит из-за скопления жидкости в животе). Терапия направлена на стабилизацию общего состояния питомца.
Тесты ПЦР (полимеразная цепная реакция).
Профилактика
К сожалению, список профилактических мер, предотвращающих развитие коронавирусной инфекции у кошек, включает самые общие пункты, касающиеся соблюдения правил гигиены и разработки грамотного рациона питания. Потому мы не будем подробно останавливаться на общеизвестных пунктах.
Несмотря на то, что коронавирус не угрожает домашним котам, заниматься их иммунитетом все равно необходимо
К тому же, владельцам одного или двух котов беспокоится о профилактике не имеет смысла, поскольку коронавирус едва ли грозит одиночно живучим животным. Однако это не означает, что здоровье и гигиену питомцев можно пускать на самотек – существует множество других инфекционных и грибковых заболеваний, которые могут поджидать кошек на каждом шагу. Укреплению иммунитета кошек часто способствуют витаминные добавки, которые можно приобрести в зоомагазинах и ветклиниках. О наиболее популярных линейках витаминов для кошек можно прочесть ниже.
Витамины для кошек и котят
Питомники
Когда речь заходит о питомниках, профилактика становится особенно актуальной, особенно учитывая настораживающую статистику заболеваний. Чтобы обеспечить максимальную безопасность своим «воспитанникам», заводчику следует придерживаться ряда рекомендаций:
прежде чем допустить новоприбывших кошек к остальным обитателям, необходимо разместить их на карантине. В этот период новички должны пройти все необходимые обследования, которые подтвердят их здоровье;
строго запрещается подселять серопозитивных особей к здоровым кошкам;
если у инфицированной самки появляются котята, их следует как можно скорее отнять от матери и, при необходимости, перевести на искусственное вскармливание.
Это может создать дополнительные трудности, но позволит спасти жизнь малышам;
предметы, которые используют кошки, необходимо регулярно прогревать и обрабатывать антисептическими средствами. Это поможет своевременно устранять вирусы, которые могут оставаться на лотках, мисках и других принадлежностях.
Вакцинация
Обыкновенно в разделе профилактики заболеваний инфекционной природы речь заходит о вакцинации, однако в данном случае говорить о ней не приходится. На данный момент не существует специальной вакцины, позволяющей кошке вырабатывать иммунитет к данному заболеванию.
Существующие варианты вакцин не дают достойного отпора коронавирусу
Единственным наиболее приемлемым вариантом является так называемая «интраназальная вакцина». Однако данный препарат показывает свою эффективность при работе с инфекционным энтеритом, в то время как перитонит, вызываемый другой формой коронавируса, остается вне зоны влияния данной вакцины. Это позволяет европейским врачам не признавать интраназальную вакцину как действенный способ борьбы с коронавирусом.
Диагностика
Для того чтобы установить точный диагноз, недостаточно опираться только на отдельные симптомы. Наблюдаемые признаки могут напоминать проявления других заболеваний, поэтому важно провести своевременный анализ на наличие коронавируса.
Среди лабораторных методов, используемых для выявления коронавируса у кошек, можно выделить гистологические исследования, серологические тесты, полимеразную цепную реакцию (ПЦР) и иммунофлюоресцентные тесты.
Метод ПЦР включает в себя анализ кала, плазмы крови, а также плевральной и асцитной жидкостей. Этот метод позволяет обнаружить даже минимальные количества вирусного генома. В крови кошек могут находиться антитела, которые борются с вирусом. Максимально допустимые уровни концентрации антител при перитоните составляют 1280.
Диагностика заболевания
Чтобы защитить здоровых кошек, а также начать лечение больных животных, нужно обнаружить вирус как можно раньше. Для этого нужно обследовать даже тех животных, у которых нет очевидных симптомов.
Конкретного анализа на выявление коронавируса у кошек не существует. Диагностика состоит из нескольких составляющих:
- метод исключения — ПЦР и ИХА (проверка экскрементов на гельминты и крови на наличие бактерий и вирусов);
- лабораторный анализ крови на наличие вирусов — ИФА и ИХА (если в крови есть антитела к вирусу, значит есть и штамм);
- титр антител (этот анализ помогает выявить конкретное количество антител, а это позволяет назначить лечение в соответствии со степенью тяжести болезни), например, при коронавирусном перитоните количество антител превышает 1200;
- тест микрофлоры на чувствительность к антибиотикам;
- диагностика лечением (если организм не реагирует положительно на симптоматическое лечение, значит нужно воздействие на вирус).
Для диагностики коронавируса нужны лабораторные исследования
Самый точный метод диагностики — биопсия и гистология поражённых тканей. Но это сложно, дорого, требует дополнительное время, к тому же далеко не в каждой клинике такой способ практикуется. Существуют «быстрые» тесты на наличие вируса, но они тоже есть не в каждой клинике. А если и есть, то требуется повторная проверка (для стопроцентного подтверждения диагноза). Однако любой даже подтверждённый диагноз будет означать лишь наличие вируса, но не его природу. Определить перитонит и энтерит может только ветеринар на основании анамнеза.
Мои знакомые, чья кошка заболела так называемой «коронкой», сдавали анализы сразу в нескольких клиниках. Дело в том, что в некоторых ветеринарных больницах проводят не все исследования, а только одно или два. Так ПЦР они сдавали в одной клинике, а титры — в другой. Это вышло накладно, но оказалось, что результаты всех анализов получились разными. В самой дорогой клинике сравнили все эти результаты и обобщили картину — кошка носитель вируса.
Какие сосудистые осложнения наиболее опасны после коронавируса?
Наиболее частым и серьезным осложнением, возникающим после перенесенного коронавируса, являются тромбозы, особенно в условиях стеноза — сужения сосудов, а также разрывы аневризм (выпячивание стенки сосуда с ее истончением). Важно понимать, что эндотелий сосудов, поврежденный вирусом, восстанавливается медленно, а процессы, происходящие в организме, создают дополнительную нагрузку на всю систему кровообращения.
Тромбы, представляющие собой желеобразные сгустки крови, клеточных элементов и белков, образуются в результате повреждения сосудов и на фоне нарушения свертываемости крови. Они могут увеличиваться в размерах и циркулировать в организме, при этом пациент зачастую не подозревает о наличии тромба.
Эти тромбы способны блокировать артерии сердца и головного мозга, что может привести к инфаркту или инсульту. Не менее опасной является тромбоэмболия легочной артерии (ТЭЛА). Часто тромбы, перекрывающие сосуды легких, изначально формируются в глубоких венах ног, а затем отрываются и перемещаются. Поэтому при появлении таких симптомов, как:
- внезапная одышка без видимой причины,
- боль в грудной клетке,
- наличие крови в мокроте при кашле,
- хрипы в груди,
- обморочные состояния, холодный пот и головокружение,
- резкое учащение пульса в состоянии покоя,
можно заподозрить именно ТЭЛА. В таких случаях пациенту настоятельно рекомендуется пройти КТ легочной артерии с контрастом. К сожалению, в большинстве случаев такая диагностика проводится уже после появления симптомов, как и диагностика инсульта. Компьютерная томография в таких ситуациях является предпочтительным методом для визуальной оценки состояния сосудов.
Симптомы коронавирусного энтерита
Коронавирусная инфекция у кошек чаще всего протекает без каких-либо жалоб, либо проявляется умеренно выраженными симптомами, связанными с воспалительным процессом в тонком кишечнике (коронавирусный энтерит) вследствие разрушения слизистой оболочки кишечника.
Проявления короновирусного энтерита у кошек:
- мягкий или жидкий стул, с примесью крови или слизи (или без примесей);
- плохой набор веса;
- плохой аппетит;
- повышенная температура.
Как правило, эти симптомы не вызывают серьезного ухудшения общего состояния и не требуют медикаментозного лечения, если речь не идет о присоединении вторичной инфекции или сопутствующих заболеваниях.
Опасность кишечного коронавируса
Данное состояние представляет опасность не только из-за воспалительного процесса, но и потому, что при рвоте и диарее организм теряет значительное количество жидкости, что может привести к обезвоживанию. Особенно уязвимыми являются пожилые люди, страдающие от хронических заболеваний. Для них такая ситуация может угрожать не только здоровью, но и жизни.
Диагностика
По аналогии с респираторной формой коронавируса, диагностика кишечной формы заболевания проводиться с помощью лабораторного ПЦР исследования
Во внимание берется характер жалоб пациента
Лечение
При респираторной форме данного заболевания чаще всего применяется комплексное симптоматическое лечение. В случаях выраженных клинических проявлений рекомендуется курс интерферонов, которые играют важную роль в поддержании иммунной системы. Восстановление водно-солевого баланса также имеет первостепенное значение. Для этого назначается обильное питье, а также препараты, содержащие необходимые электролиты. Одним из самых популярных средств является Регидрон в виде порошка для приготовления раствора, который используется для регидратации при диарее, независимо от ее причин. Селен, обладающий доказанной эффективностью, помогает повысить общую устойчивость организма при лечении всех форм Covid-19.
Диета является неотъемлемой частью комплексного лечения. Пациентам рекомендуется щадящий режим питания, который исключает жареную и жирную пищу, алкоголь, приправы и соусы. Для поддержания здоровья кишечника предпочтение отдается слизистым супам, кашам на воде, отварной рыбе, молочным киселям и другим продуктам, которые обволакивают стенки желудочно-кишечного тракта.
При любых проявлениях кишечного коронавируса важно не откладывать визит к врачу. Независимо от первичной или вторичной природы заболевания, это состояние нарушает баланс кишечной и желудочной микрофлоры, что может провоцировать или усугублять диарею.
Для восстановления микрофлоры кишечника рекомендуется принимать метапребиотик Стимбифид Плюс. Этот препарат содержит три активных компонента, которые эффективно восстанавливают баланс микрофлоры кишечника человека.
Нормальная микрофлора способствует ускорению выздоровления при кишечной форме коронавирусной инфекции, укрепляет защитные силы организма и предотвращает обезвоживание. Эффективность метапребиотика подтверждена как при лечении кишечной формы коронавируса, так и для его профилактики. Стимбифид Плюс безопасен для использования в любом возрасте. Полный курс приема этого метапребиотика поможет минимизировать риск осложнений как респираторной, так и кишечной форм коронавирусной инфекции.
Болеют ли котята и как их лечат
Котята тоже болеют коронавирусом
Коронавирусная инфекция мало избирательна в плане выбора объекта поражения. Любое животное, независимо от породной принадлежности и возраста, может ей заболеть. До сих пор ученые «ломают голову», почему некоторые организмы более устойчивы. Но исходя из ветеринарной практики, можно выделить наиболее уязвимые группы кошек: альбиносы, мужские особи преклонного возраста и котята.
Несмотря на невозможность заражаться в утробе матери, спустя месяц после рождения котик способен заболеть коронавирусом. Обычно симптоматика явно проявляется при отрыве малыша от кошки-матери. Котята до полутора лет имеют ослабленный иммунитет, так что в случае вирусного поражения организм не в силах противостоять возбудителю. Иммунная защита стабилизируется у котов к двум годам.
Профилактика заболевания
Компания Pfizer представила уникальную интраназальную вакцину Primucell, предназначенную для защиты от коронавируса. Тем не менее, ветеринары предупреждают, что владельцы привитых кошек не могут рассчитывать на полную защиту. Это связано с несколькими важными факторами:
- Примуцел разработан для предотвращения коронавирусного перитонита.
- Если кот уже инфицирован, вакцина может вызвать развитие инфекционного процесса.
- Научные исследования пока не подтвердили эффективность Примуцела.
Большинство ветеринаров советуют предотвращать коронавирусную инфекцию, следуя простым рекомендациям:
- обеспечить комфортные условия для жизни кошки (чистота, сухость и т.д.);
- кормить животное сбалансированным рационом, богатым витаминами и микроэлементами;
- соблюдать основные правила гигиены;
- регулярно дезинфицировать место обитания питомца;
- перед тем как поселить нового котёнка, показать его ветеринару;
- избегать контакта домашней кошки с бездомными животными;
- поддерживать иммунитет кошки, своевременно лечить все болезни;
- периодически проводить обработку от блох и глистов;
- минимизировать стрессовые ситуации, так как они ослабляют иммунную систему.
Коронавирус у кошек представляет собой вирусную инфекцию, чаще всего встречающуюся у котят и молодых особей до 2 лет. Вирус проникает в организм и может привести к хронической форме заболевания. При ослаблении иммунитета и наличии других неблагоприятных факторов вирус мутирует, что приводит к более тяжелым и осложнённым формам болезни. Наиболее распространёнными симптомами коронавируса являются инфекционный перитонит и энтерит. Лечение в этих случаях обычно симптоматическое и антибактериальное, однако не всегда приносит желаемый результат, и многие кошки могут погибнуть от этого заболевания.
Рекомендации по уходу за больными кошками
Уход за кошками, заболевшими коронавирусом, требует особого внимания и заботы. Важно помнить, что коронавирус у кошек может проявляться в различных формах, и в зависимости от состояния животного, уход может варьироваться. Вот несколько рекомендаций, которые помогут обеспечить комфорт и поддержку вашему питомцу в период болезни.
Создание комфортной среды
Первое, что необходимо сделать, это создать для больной кошки спокойную и уютную обстановку. Выделите ей отдельное место в доме, где она сможет отдохнуть и восстановиться. Убедитесь, что это место защищено от сквозняков и лишнего шума. Используйте мягкие подстилки и одеяла, чтобы обеспечить тепло и комфорт.
Обеспечение доступа к воде и пище
Кошки, страдающие от коронавирусной инфекции, могут испытывать потерю аппетита. Однако важно следить за тем, чтобы питомец имел постоянный доступ к свежей воде. Если кошка отказывается от корма, попробуйте предложить ей более ароматные и аппетитные варианты, такие как консервы или специальный лечебный корм. В некоторых случаях может потребоваться использование шприца для кормления, если животное совсем не ест.
Мониторинг состояния здоровья
Регулярно проверяйте состояние здоровья вашей кошки. Обратите внимание на такие симптомы, как изменение поведения, уровень активности, наличие рвоты, диареи или других признаков дискомфорта. Если вы заметили ухудшение состояния, немедленно обратитесь к ветеринару. Важно следить за температурой тела, которая может повышаться при инфекции.
Лекарственная терапия
Следуйте рекомендациям ветеринара относительно назначения лекарств. В зависимости от состояния вашей кошки, могут быть назначены противовирусные препараты, антибиотики для предотвращения вторичных инфекций или другие медикаменты. Не забывайте о важности соблюдения дозировок и режима приема лекарств.
Поддержка иммунной системы
Для поддержки иммунной системы вашей кошки можно использовать специальные добавки и витамины, рекомендованные ветеринаром. Это может помочь организму справиться с инфекцией и ускорить процесс выздоровления. Также важно обеспечить питомцу полноценное питание, богатое необходимыми питательными веществами.
Изоляция от других животных
Если у вас есть другие домашние животные, рекомендуется изолировать больную кошку, чтобы предотвратить распространение вируса. Обеспечьте ей отдельный туалет, миски для еды и воды, а также игрушки. Это поможет минимизировать риск заражения других животных в доме.
Психологическая поддержка
Не забывайте о важности эмоциональной поддержки для вашей кошки. Проведите больше времени рядом с ней, гладьте и разговаривайте с ней. Это поможет снизить уровень стресса и улучшить общее самочувствие. Кошки чувствуют настроение своих хозяев, поэтому старайтесь сохранять спокойствие и уверенность.
Следуя этим рекомендациям, вы сможете обеспечить своей кошке необходимый уход и поддержку в период болезни, что поможет ей быстрее восстановиться и вернуться к привычной жизни.
Вопрос-ответ
Каковы симптомы коронавируса у кошек?
Симптомы коронавируса у кошек могут включать в себя респираторные проявления, такие как кашель и затрудненное дыхание, а также gastrointestinalные симптомы, такие как рвота и диарея. Также могут наблюдаться потеря аппетита, вялость и лихорадка. Важно отметить, что многие кошки могут быть бессимптомными носителями вируса.
Какой самый первый признак коронавируса?
Первые симптомы коронавируса: сильная слабость, головная боль, кашель. Никогда не вызывали столько тревоги, как в период пандемии COVID-19. Его симптомы похожи на проявления обыкновенной простуды, ОРВИ, гриппа, аллергии, поэтому заболевания можно спутать.
Сколько длится вирусная инфекция у кота?
Возникает у котят и длится около 2-4 недель, сопровождается поносом. К смертельному исходу приводит довольно редко. У взрослых кошек инфекция протекает бессимптомно. У переболевших животных развивается иммунитет.
Советы
СОВЕТ №1
Регулярно наблюдайте за состоянием вашего питомца. Обратите внимание на любые изменения в поведении, аппетите или активности. Если вы заметили симптомы, такие как кашель, чихание или потеря аппетита, немедленно обратитесь к ветеринару.
СОВЕТ №2
Поддерживайте чистоту в доме и следите за гигиеной вашего кота. Регулярно мойте его миски, игрушки и лоток, чтобы снизить риск распространения инфекции. Также старайтесь ограничить контакты с другими животными, особенно если они могут быть потенциальными носителями вируса.
СОВЕТ №3
Обеспечьте вашему питомцу сбалансированное питание и достаточное количество воды. Хорошее питание укрепляет иммунную систему, что может помочь вашему коту справиться с инфекцией. Проконсультируйтесь с ветеринаром о подходящих кормах и добавках.
СОВЕТ №4
Следите за вакцинацией вашего кота. Хотя специфическая вакцинация против коронавируса у кошек не всегда доступна, регулярные прививки от других инфекционных заболеваний помогут защитить вашего питомца и снизить риск осложнений.
Уход за кошками, заболевшими коронавирусом, требует особого внимания и заботы. Важно помнить, что коронавирус у кошек может проявляться в различных формах, и в зависимости от состояния животного, уход может варьироваться. Вот несколько рекомендаций, которые помогут обеспечить комфорт и поддержку вашему питомцу в период болезни.
Первое, что необходимо сделать, это создать для больной кошки спокойную и уютную обстановку. Выделите ей отдельное место в доме, где она сможет отдохнуть и восстановиться. Убедитесь, что это место защищено от сквозняков и лишнего шума. Используйте мягкие подстилки и одеяла, чтобы обеспечить тепло и комфорт.
Кошки, страдающие от коронавирусной инфекции, могут испытывать потерю аппетита. Однако важно следить за тем, чтобы питомец имел постоянный доступ к свежей воде. Если кошка отказывается от корма, попробуйте предложить ей более ароматные и аппетитные варианты, такие как консервы или специальный лечебный корм. В некоторых случаях может потребоваться использование шприца для кормления, если животное совсем не ест.
Регулярно проверяйте состояние здоровья вашей кошки. Обратите внимание на такие симптомы, как изменение поведения, уровень активности, наличие рвоты, диареи или других признаков дискомфорта. Если вы заметили ухудшение состояния, немедленно обратитесь к ветеринару. Важно следить за температурой тела, которая может повышаться при инфекции.
Следуйте рекомендациям ветеринара относительно назначения лекарств. В зависимости от состояния вашей кошки, могут быть назначены противовирусные препараты, антибиотики для предотвращения вторичных инфекций или другие медикаменты. Не забывайте о важности соблюдения дозировок и режима приема лекарств.
Для поддержки иммунной системы вашей кошки можно использовать специальные добавки и витамины, рекомендованные ветеринаром. Это может помочь организму справиться с инфекцией и ускорить процесс выздоровления. Также важно обеспечить питомцу полноценное питание, богатое необходимыми питательными веществами.
Если у вас есть другие домашние животные, рекомендуется изолировать больную кошку, чтобы предотвратить распространение вируса. Обеспечьте ей отдельный туалет, миски для еды и воды, а также игрушки. Это поможет минимизировать риск заражения других животных в доме.
Не забывайте о важности эмоциональной поддержки для вашей кошки. Проведите больше времени рядом с ней, гладьте и разговаривайте с ней. Это поможет снизить уровень стресса и улучшить общее самочувствие. Кошки чувствуют настроение своих хозяев, поэтому старайтесь сохранять спокойствие и уверенность.
Следуя этим рекомендациям, вы сможете обеспечить своей кошке необходимый уход и поддержку в период болезни, что поможет ей быстрее восстановиться и вернуться к привычной жизни.
Уход за кошками, заболевшими коронавирусом, требует особого внимания и заботы. Важно помнить, что коронавирус у кошек может проявляться в различных формах, и в зависимости от состояния животного, уход может варьироваться. Вот несколько рекомендаций, которые помогут обеспечить комфорт и поддержку вашему питомцу в период болезни.
Первое, что необходимо сделать, это создать для больной кошки спокойную и уютную обстановку. Выделите ей отдельное место в доме, где она сможет отдохнуть и восстановиться. Убедитесь, что это место защищено от сквозняков и лишнего шума. Используйте мягкие подстилки и одеяла, чтобы обеспечить тепло и комфорт.
Кошки, страдающие от коронавирусной инфекции, могут испытывать потерю аппетита. Однако важно следить за тем, чтобы питомец имел постоянный доступ к свежей воде. Если кошка отказывается от корма, попробуйте предложить ей более ароматные и аппетитные варианты, такие как консервы или специальный лечебный корм. В некоторых случаях может потребоваться использование шприца для кормления, если животное совсем не ест.
Регулярно проверяйте состояние здоровья вашей кошки. Обратите внимание на такие симптомы, как изменение поведения, уровень активности, наличие рвоты, диареи или других признаков дискомфорта. Если вы заметили ухудшение состояния, немедленно обратитесь к ветеринару. Важно следить за температурой тела, которая может повышаться при инфекции.
Следуйте рекомендациям ветеринара относительно назначения лекарств. В зависимости от состояния вашей кошки, могут быть назначены противовирусные препараты, антибиотики для предотвращения вторичных инфекций или другие медикаменты. Не забывайте о важности соблюдения дозировок и режима приема лекарств.
Для поддержки иммунной системы вашей кошки можно использовать специальные добавки и витамины, рекомендованные ветеринаром. Это может помочь организму справиться с инфекцией и ускорить процесс выздоровления. Также важно обеспечить питомцу полноценное питание, богатое необходимыми питательными веществами.
Если у вас есть другие домашние животные, рекомендуется изолировать больную кошку, чтобы предотвратить распространение вируса. Обеспечьте ей отдельный туалет, миски для еды и воды, а также игрушки. Это поможет минимизировать риск заражения других животных в доме.
Не забывайте о важности эмоциональной поддержки для вашей кошки. Проведите больше времени рядом с ней, гладьте и разговаривайте с ней. Это поможет снизить уровень стресса и улучшить общее самочувствие. Кошки чувствуют настроение своих хозяев, поэтому старайтесь сохранять спокойствие и уверенность.
Следуя этим рекомендациям, вы сможете обеспечить своей кошке необходимый уход и поддержку в период болезни, что поможет ей быстрее восстановиться и вернуться к привычной жизни.